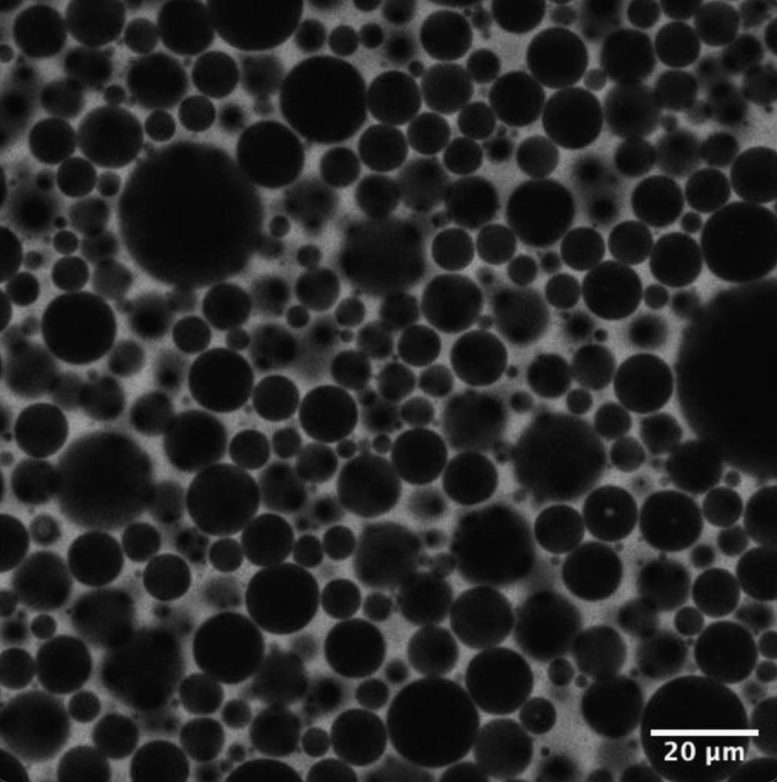
Microscopic Bubbles Moving in Foam

Table of Contents

Scientists have long believed that foam behaves like glass, with bubbles locked into place. New simulations reveal that bubbles never truly settle and instead keep moving through many possible arrangements.
Even more unexpected, this motion follows the same mathematics that allow AI systems to learn. The finding hints that learning may be a broader principle found across nature and technology.
Foam Is Familiar but Misunderstood
Foams show up in many everyday forms, including soap suds, shaving cream, whipped toppings, and food emulsions like mayonnaise. For decades, scientists believed these materials behaved much like glass, with their microscopic parts locked into disordered yet motionless arrangements.
That long-held assumption is now being challenged. Engineers at the University of Pennsylvania have discovered that foams remain in constant internal motion, even as they maintain a stable outer shape. From a mathematical standpoint, this hidden movement closely resembles deep learning, the approach commonly used to train modern AI systems.
The finding suggests that learning, when viewed as a mathematical process, may be a shared organizing principle across physical materials, living systems, and computational models. It also points toward new ways to think about designing materials that can adapt over time. In addition, the work may offer insights into biological structures that must continually reorganize, such as the internal framework of living cells.
Bubbles That Keep Rearranging
In research published in Proceedings of the National Academy of Sciences, the team used computer simulations to follow the paths of bubbles inside a wet foam. Instead of settling into fixed positions, the bubbles continued to wander through a wide range of possible arrangements.
From a mathematical perspective, this behavior closely matches how deep learning systems operate. During training, an AI repeatedly adjusts its parameters – the information that encodes what an AI “knows” – rather than locking into a final configuration.
“Foams constantly reorganize themselves,” says John C. Crocker, Professor in Chemical and Biomolecular Engineering (CBE) and the paper’s co-senior author. “It’s striking that foams and modern AI systems appear to follow the same mathematical principles. Understanding why that happens is still an open question, but it could reshape how we think about adaptive materials and even living systems.”
Why Traditional Foam Models Fell Short
At the scale we can see and touch, foams often behave like solids. They generally hold their shape and can spring back when pressed. At much smaller scales, however, foams are classified as “two-phase” materials, consisting of bubbles suspended in a liquid or solid background.
Because foams are easy to produce and observe while still displaying complex mechanical behavior, scientists have long used them as simplified models for studying other dense and dynamic systems, including living cells.
Older theories described foam bubbles as if they were heavy objects moving across an energy landscape. In this picture, bubbles roll downhill into positions that require less energy and then remain there. This framework helped explain why foams appear stable once formed, much like a boulder resting at the bottom of a valley.

A Longstanding Puzzle in Foam Physics
Closer examination of experimental data revealed a problem. The actual behavior of foams did not match what these theories predicted.
“When we actually looked at the data, the behavior of foams didn’t match what the theory predicted,” says Crocker. “We started seeing these discrepancies nearly 20 years ago, but we didn’t yet have the mathematical tools to describe what was really happening.”
Resolving this conflict required a new way of thinking, one capable of describing systems that continue to change without ever settling into a single, permanent state.
Insights Borrowed From Artificial Intelligence
Modern AI systems learn by continuously adjusting numerical parameters during training. Early training methods aimed to push these systems toward a single best solution that perfectly matched their training data.
Deep learning relies on optimization techniques related to a mathematical method known as gradient descent. These algorithms repeatedly guide a system toward configurations that reduce error, moving step by step toward better performance. If learning were visualized as a landscape, the process would resemble traveling downhill toward improved solutions.
Over time, researchers discovered that forcing systems into the deepest possible solutions caused problems. Models that fit their training data too closely often struggled to handle new situations.
“The key insight was realizing that you don’t actually want to push the system into the deepest possible valley,” says Robert Riggleman, Professor in CBE and co-senior author of the study. “Keeping it in flatter parts of the landscape, where lots of solutions perform similarly well, turns out to be what allows these models to generalize.”
Foam and AI Share the Same Mathematics
When the Penn researchers reanalyzed their foam simulations using this framework, the similarity became clear. Foam bubbles do not settle into deep, stable positions. Instead, they remain in motion within broad regions where many configurations are equally viable.
This behavior closely mirrors how modern AI systems learn. The same mathematics that explains why deep learning is effective also captures the ongoing rearrangement taking place inside foam.
Implications for Adaptive Materials and Biology
The study offers new insights in a field that many believed was already well understood. That challenge to conventional thinking may be one of its most important contributions.
By showing that foam bubbles are not trapped in glass-like states but instead move in ways similar to learning algorithms, the research encourages scientists to reconsider how other complex systems might behave under this mathematical lens.
Crocker’s team is now revisiting the system that originally sparked his interest in foams: the cytoskeleton, the microscopic scaffolding inside cells that supports life. Like foam, the cytoskeleton must continually reorganize itself while preserving its overall structure.
“Why the mathematics of deep learning accurately characterizes foams is a fascinating question,” says Crocker. “It hints that these tools may be useful far outside of their original context, opening the door to entirely new lines of inquiry.”
Reference: “Slow relaxation and landscape-driven dynamics in viscous ripening foams” by Amruthesh Thirumalaiswamy, Clary Rodríguez-Cruz, Robert A. Riggleman and John C. Crocker, 20 November 2025, Proceedings of the National Academy of Sciences.
DOI: 10.1073/pnas.2518994122
This research was conducted at the University of Pennsylvania School of Engineering and Applied Science and supported by the National Science Foundation Division of Materials Research (1609525, 1720530).
Additional co-authors include Amruthesh Thirumalaiswamy and Clary Rodríguez-Cruz.
Never miss a breakthrough: Join the SciTechDaily newsletter.
Follow us on Google and Google News.

